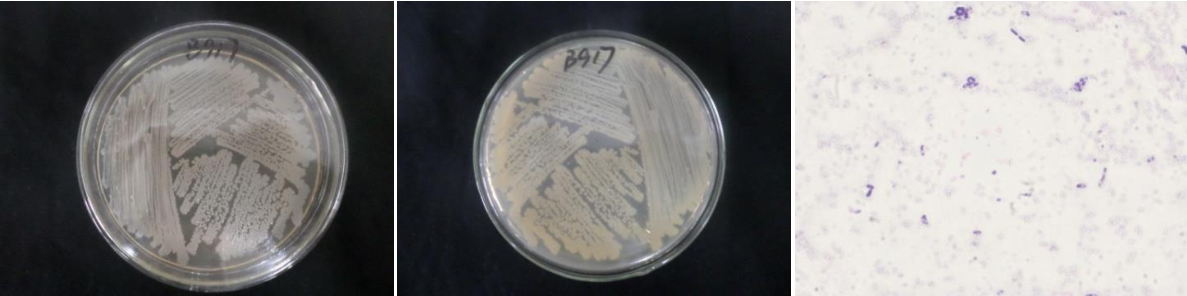

Loading...
| StrainNO | B917 |
| Classification | Bacillus |
| 16s rDNA sequence | CGGCTGGCTCCAAAAAGGTTACCCCACCGACTTCGGGTGTTACAAACTCTCGTGGTGTGACGGGCGGTGTGTACAAGGCCCGGG AACGTATTCACCGCGGCATGCTGATCCGCGATTACTAGCGATTCCAGCTTCATGTAGGCGAGTTGCAGCCTACAATCCGAACTG AGAACGGTTTTATGAGATTAGCTCCACCTCGCGGTCTTGCAGCTCTTTGTACCGTCCATTGTAGCACGTGTGTAGCCCAGGTCA TAAGGGGCATGATGATTTGACGTCATCCCCACCTTCCTCCGGTTTGTCACCGGCAGTCACCTTAAAGTGCCCAACTTAATGATG GCAACTAAAATCAAGGGTTGCGCTCGTTGCGGGACTTAACCCAACATCTCACGACACGAGCTGACGACAACCATGCACCACCTG TCACTCTGCTCCCGAAGGAGAAGCCCTATCTCTAGGGTTTTCAAAGGATGTCAAGACCTGGTAAGGTTCTTCGCGTTGCTTCGA ATTAAACCACATGCTCCACCGCTTGTGCGGGCCYYYGTCAATTCCTTTGAGTTTCAGCCTTGCGGCCGTACTCCCCAGGCGGAG TGCTTAATGCGTTAACTTCAGCACTAAAGGGCGGAAACCCTCTAACACTTAGCACTCATCGTTTACGGCGTGGACTACCAGGGT ATCTAATCCTGTTTGCTCCCCACGCTTTCGCGCCTCAGTGTCAGTTACAGACCAGAAAGTCGCCTTCGCCACTGGTGTTCCTCC ATATCTCTACGCATTTCACCGCTACACATGGAATTCCACTTTCCTCTTCTGCACTCAAGTCTCCCAGTTTCCAATGACCCTCCA CGGTTGAGCCGTGGGgCTTTCACATCAGACTTAAGAAACCACCTGCGCGCGCTTTACGCCCAATAATTCCGGATAACGCTTGCC ACCTACGTATTACCGCGGCTGCTGGCACGTAGTTAGCCGTGGCTTTCTGGTTAGGTACCGTCAAGGTGCCAGCTTATTCAACTA GCACTTGTTCTTCCCTAACAACAGAGTTTTACGACCCGAAAGCCTTCATCACTCACGCGGCGTTGCTCCGTCAGACTTTCGTCC ATTGCGGAAGATTCCCTACTGCTGCCTCCCGTAGGAGTCTGGGCCGTGTCTCAGTCCCAGTGTGGCCGATCACCCTCTCAGGTC GGCTACGCATCGTTGCCTTGGTGAGCCGTTACCTCACCAACTAGCTAATGCGACGCGGGTCCATCCATAAGTGACAGCCGAAGC CGCCTTTCAATTTCGAACCATGCGGTTCAAAATGTTATCCGGTATTAGCCCCGGTTTCCCGGAGTTATCCCAGTCTTATGGGCA GGTTACCCACGTGTTACTCACCCGTCCGCCGCTAACTTCATAAGAGCAAGCTCTTAATCCATTCGCTCGACTTGCATG |
| Strain Morphology Photos | |
| Morphological Description | The morphology of Colony round;lime white;edge serrated;slightly convex;center convex;wrinkled;slippy;sticky;waxy;The morphology of strain:Rod;having spore;spore mesophytic |